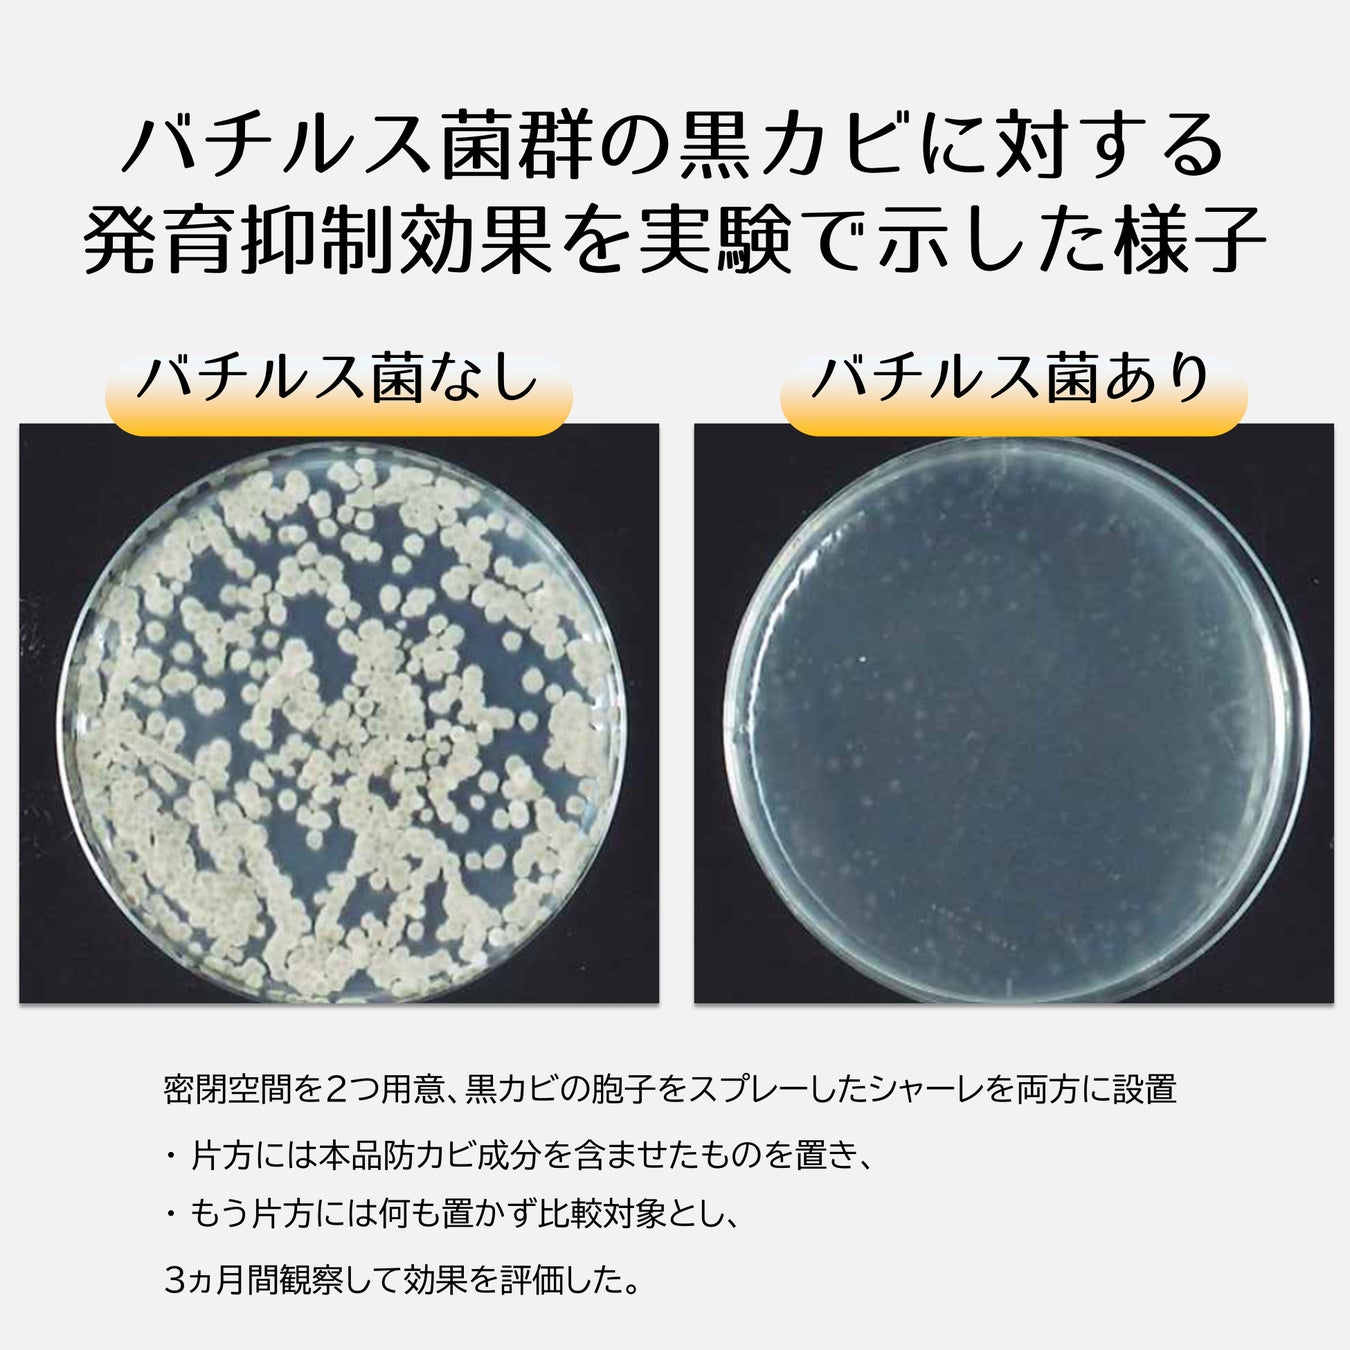

梅雨時期の必需品 防カビ・消臭の“ハイブリッド防カビ剤”「家じゅう置くだけ 防カビ 消臭ビーズ」新発売! ヒット商品に消臭効果をプラス
〜自然素材・無香でお風呂以外にも設置 約3ヶ月の長持ち効果〜

地球環境と身体にやさしい家庭用品メーカーの株式会社丹羽久(本社:岐阜県恵那市、代表取締役社長:丹羽 誠)は、ヒット商品「家じゅう置くだけ 防カビ ビーズ」に消臭効果を加えた「家じゅう置くだけ 防カビ 消臭ビーズ」を、全国のドラッグストア、スーパーマーケット、ホームセンター、オンラインストアなどで順次販売します。
「家じゅう置くだけ 防カビ 消臭ビーズ」は、①無臭タイプだから家じゅうどこでも使える、②カビ臭に限らず様々な生活臭を消すという機能を併せ持つ“ハイブリッド防カビ剤”として、梅雨時期の湿気と臭いを除去します。
■開発の背景
一般的な家庭用防カビ剤は、従来の燻煙タイプに代わり据置型等の簡便な製品が登場することで、多くの家庭でご利用されるようになりましたが、「薬剤臭が強く浴室以外で使いにくい」「消臭効果はあっても “カビ臭”だけに限定されている」といった声もあがっておりました。
そうした中で、「手軽に置ける」「匂いが気にならない」等とご好評のヒット商品「家じゅう置くだけ 防カビ ビーズ」に消臭効果を加えた「家じゅう置くだけ 防カビ 消臭ビーズ」の開発・販売に至りました。




■特長
防カビ剤に消臭効果をプラスした“ハイブリッド防カビ剤”
・大手ECサイトで年間約2.3万個販売!「手軽に置ける」「匂いが気にならない」とご好評の既存の防カビ剤「家じゅう置くだけ 防カビ ビーズ」に消臭効果をプラス
・「置き型防カビ剤」と「カビ臭を防ぐ」両方の効果で、カビ臭以外の生活臭も消臭
自然素材・無香でお風呂以外にも設置
・天然由来の成分“バチルス菌”で、だれでもどこでも安心して使用可能
・外部研究機関においてカビ抑制効果を検証、実効性も確認済み
弊社商品のカビを抑えるビーズの秘密は、バイオベンチャーが開発に成功したバチルス菌技術です。バチルス菌は天然由来の成分で作られており、水と反応すると覚醒し、カビ菌を抑制し長く効果を出し続けます。
■製品概要
商品名:家じゅう置くだけ 防カビ 消臭ビーズ
容量:130g
使用期間:約3ヶ月
液性:弱アルカリ性
主成分:バチルス菌等有用微生物群、吸水性樹脂、ミネラル水
用途:浴室、洗面所、トイレ、下駄箱、シンク下等
希望小売価格: 698円(税抜)
販売場所: 2026年3月31日よりメーカー出荷開始。全国のドラッグストア、スーパーマーケット、ホームセンター、オンラインストア等にて順次販売予定
すべての画像
